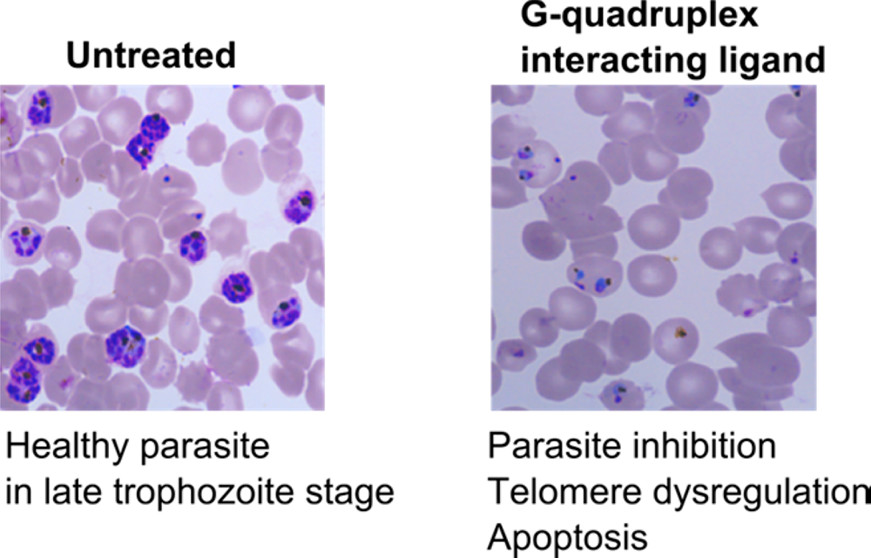

Publications
66.Bagale, S. S.; Deshmukh, P. U.; Mandal, S.; Malvi, H.; Kondabagil, K.; Pradeepkumar, P.I."Synthesis of N6-dA damaged DNAs to probe the replication ability of human translesion polymerases" J. Org. Chem. 2024 (Under revision)

62.Kumar, S.; Biswas, A.; Sudhakar, S.; Kumari, D.; Pradeepkumar, P.I. "Estrone-Based Derivatives Stabilize the c-MYC and c-KIT G-Quadruplex DNA Structures" ACS Omega 2024, 9, 6616–6616.

59. Sudhakar, S.; Barkau, C. L.; Chilamkurthy, R.; Barber, H. M.; Pater, A. A.; Moran, S. D.; Damha, M. J.; Pradeepkumar, P. I.; Gagnon, K. T. "Binding to the Conserved and Stably Folded Guide RNA Pseudoknot Induces Cas12a Conformational Changes During Ribonucleoprotein Assembly."J. Biol. Chem. 2023, 104700.
51. Habibian,M.; Harikrishna, S.; Fakhoury, J.; Barton, M.; Ageely, E. A.; Cencic, R.; Fakih, H. H.; Katolik, A.; Takahashi, M.; Rossi, J.; Pelletier, J.; Gagnon, K.T. Pradeepkumar, P.I.; Damha, M. J."Effect of 2′-5′/3′-5′ phosphodiester linkage heterogeneity on RNA interference"Nucleic Acids Res. 2020, 48, 4643–4657.
44. Pratibha P. Ghodke; Pradeepkumar, P. I."Nucleosides Modification Using Buchwald-Hartwig Amination Reactions""Palladium-Catalyzed Modification of Nucleosides, Nucleotides and Oligonucleotides", Elsevier, Chapter 10, pp 295-334 2018

38. Malhotra, R.; Rarhia, C.; Diveshkumar , K.V.; Barikb, R.; D’cunha, R.; Dharb, P.; Kundu, M.; Chattopadhyay, S.; Royb, S; Basub, S.; Pradeepkumar, P.I.,Hajrad, S."Dihydrochelerythrine and its Derivatives: Synthesis and Their Application as Potential G-quadruplex DNA Stabilizing agents"Bioorg. Med. Chem., 2016, 24, 2887–2896
24. Gore K.R ; Nair D.T ; Pradeepkumar P.I.; "Synthesis of N2-furfuryl doxyguanosine phosphoramidite and modified oligonucleotides "Indian Patent Application No.: 0454/MUM/2013 dated February 18, 2013
20. Hobartner, C; Pradeepkumar, P. I."DNA Catalysts for Practical Application in Bioorganic Chemistry in New Strategies in Chemical Synthesis and Catalysis (Pigantaro, B. Ed.)"Wiley-VCH. Chapter 6, pp 129-150 2012

19. Pradeepkumar, P. I.; Hobartner, C."RNA Cleaving DNA Enzymes and their Potential Therapeutic Applications as Antibacterial and Antiviral Agents in From Nucleic Acids Sequences to Molecular Medicine(Erdmann, V. A, Barciszewski, J. Eds.)"Springer Book Series in RNA Technologies, Springer DE. Chapter 15, pp 371-410 2012

13.Isaksson, J.; Plashkevych, O.; Pradeepkumar, P. I.; Chatterjee, S.; Barman, J.; Pathmasri, W.; Shrivastava, P.; Petit, C.; Chattopadhyaya, J."Oxetane locked thymidine in the Dickerson-Drew dodecamer causes local base pairing distortions - an NMR structure and hydration study"J. Biomol. Struct. Dyn. 2005, 23, 299-330.
12. Pradeepkumar, P. I.; Cheruku, P.; Plashkevych, O.; Acharya, P.; Gohil, S.; Chattopadhyaya, J."Synthesis,physicochemical and biochemical studies of 1',2'-oxetane constrained adenosine and guanosine modified oligonucleotides, and their comparison with those of the corresponding cytidine and thymidine analogs"J. Am. Chem. Soc. 2004, 126, 11484-11499.
11. Opalinska, J. B.; Kalota, A.; Rodriquez, L.; Henningson, C.; Gifford, L. K.; Lu,P.; Jen, K-Y.; Pradeepkumar, P. I.; Barman, J.; Kim, T. K.; Swider, C.;Chattopadhyaya, J.; Gewirtz, A.M."Rationally targeted, conformationally constrained, oxetane modified oligonucleotides are highly efficient gene silencing molecules,"Nucleic Acids Res., 2004, 32: 5791–5799.